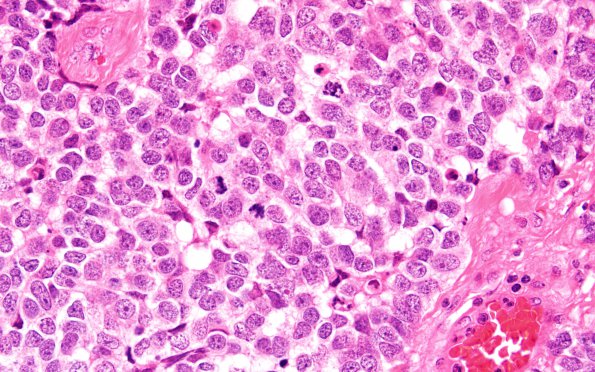
11A3 (Case 11) H&E 60X

Table of Contents
Washington University Experience | NEOPLASMS (PINEAL) | Pineoblastoma | 11A3 (Case 11) H&E 60X
Higher magnification tumor image (H&E) ---- Ancillary data (not shown): There is diffuse strong immunoreactivity for synaptophysin, and a stain for neurofilament highlights numerous tumor cell processes/axons. A Ki-67 immunostain confirms a markedly elevated proliferative rate. Stains for epithelial membrane antigen (EMA), glial fibrillary acidic protein (GFAP) and placental-like alkaline phosphatase (PLAP) are negative.